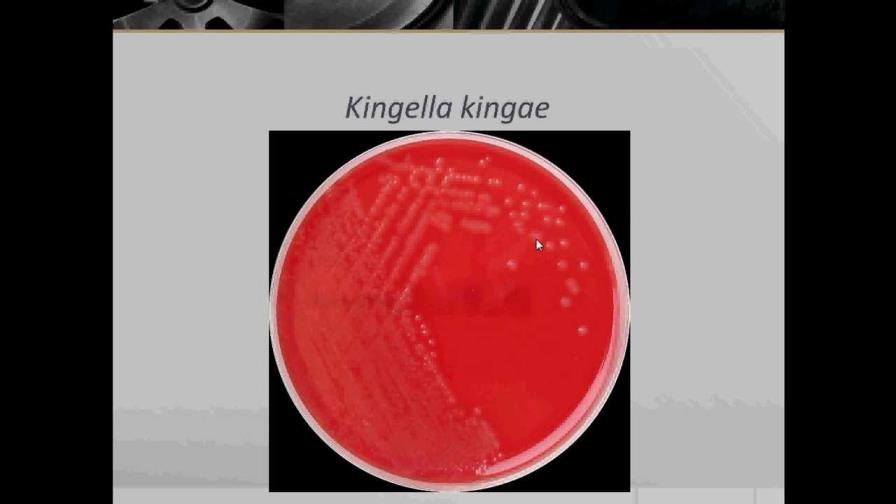
Infección por Kingella-Kingae

Infección por Kingella-Kingae
En los últimos tiempos se han detectado brotes de bacteriemia y septicemia, infecciones articulares, endocarditis y casos fatales de meningitis en niños que asisten a Day care y guarderías, producidos por una bacteria emergente que tiene predilección por niños menores de tres años de edad. Esta bacteria es un cocobacilo Gram negativo conocido como Kingella Kingae que habita normalmente en la orofaringe. Su nombre es en honor a Elizabeth O. King quien lo descubrió en 1976, aunque ya se había aislado en el año 1960. Y no es sino hasta la década de los noventa cuando se le reconoce como causante de estas importantes infecciones.
Hay estudios que han revelado que entre el 10% - 12% de la población pediátrica sana de Israel y Suiza alberga esta bacteria en niños entre los 12 y 24 meses de edad. Es excepcional por debajo de los seis meses debido a la protección que le dan los anticuerpos maternos al lactante, y, en niños mayores y adultos, por la inmunidad que les ha proporcionado una exposición recurrente y la madurez de su sistema inmunológico.
En Day Care y guarderías, donde los niños se juntan y a menudo se pasan objetos unos a otros, es donde más comúnmente se presentan brotes con una preferencia estacional entre febrero y abril. Afecta a niños debajo de los 5 años y sobre todo a menores de 2 años. La infección puede pasar desapercibida, con poca sintomatología, fiebre que no es alta, como si se tratara de una simple infección respiratoria, hasta que se localiza en la sangre, en el corazón o en una articulación mayor como la rodilla o la cadera. Estos son aspectos que dificultan el diagnostico, que muchas veces es tardío.
En conclusión, padres y médicos debemos saber que existe una bacteria emergente en la que hay que pensar si el niño se enferma en el maternal. Saber, que en principio cursa con pocos síntomas, para luego focalizarse pudiendo convertirse en una enfermedad grave. Tampoco es para alarmarse y no llevar el niño al maternal. Pero sí, para tomarlo en cuenta, como una de las infecciones virales o bacterianas que se pueden adquirir cuando se convive en grupos. Si no está vacunado y si las condiciones del establecimiento y su personal no son las mejores, el niño es más susceptible. Pero, aún en las condiciones más optimas, hay que entender, que el niño no está exento de enfermarse.
REFERENCIA: “Outbreaks of invasive Kingella Kingae infections in Day Care facilities” Pablo Yagupsky, MD and Cols. Journal of Pediatrics, March 2017. Vol. 182 pages 14-20. / M. Carmen Otero Reigada y colaboradores “Infecciones por Kingella Kingae en la edad pediátrica”, Hospital Infantil La Fe, Valencia, España.
El autor es pediatra. Puede hacer sus preguntas por email a marcosdiazguillen@gmail.com
Marcos Díaz Guillén
Marcos Díaz Guillén